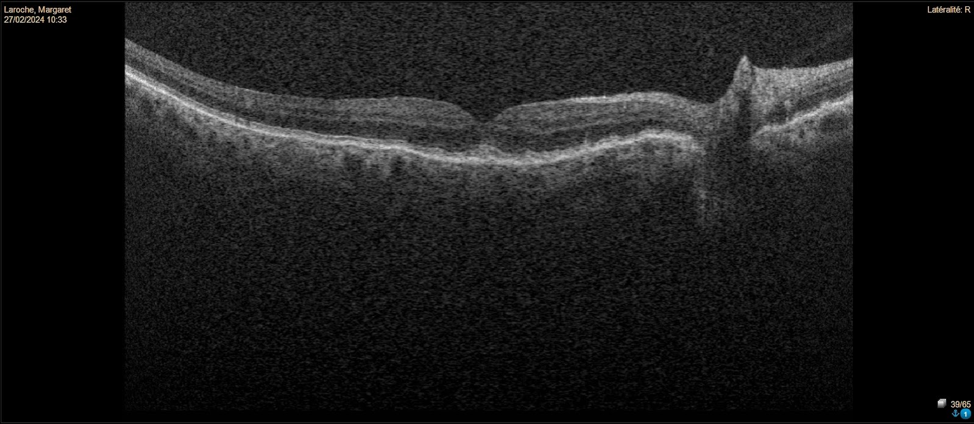
Care1 blog: Vision Changes Near the Optic Nerve
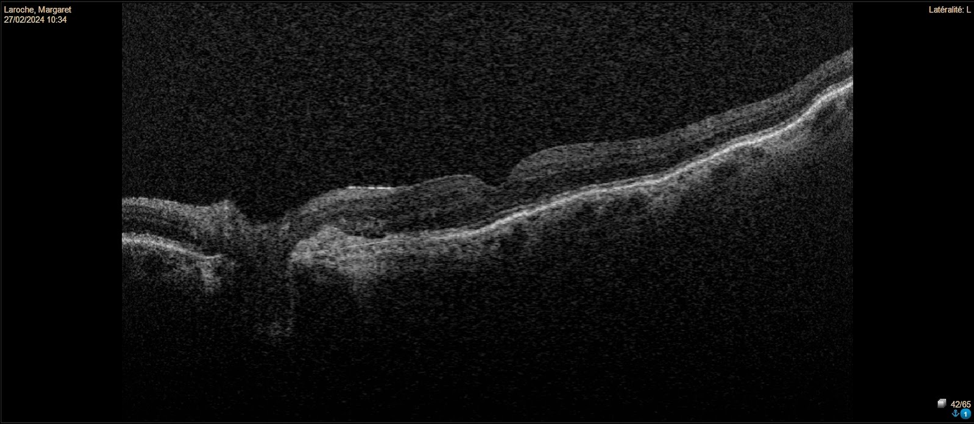
Care1 blog: Vision Changes Near the Optic Nerve

A 90-year-old female presented for her annual eye exam with no complaints. The optometrist noted longstanding dry age-related macular degeneration (AMD) in the right eye and detected some subretinal fluid adjacent to the optic nerve head in the left eye.
A retina specialist provided a virtual consult within 1-2 weeks through Care1. Scroll below to see their diagnosis.

This patient has peripapillary choroidal neovascularization (CNV) in the left eye. Fundus photos reveal drusen and pigmentary changes consistent with dry AMD in the right eye. The left eye shows peripapillary atrophy suggesting a chronic process. OCT imaging of the right eye shows drusenoid pigment epithelial detachments (PEDs), while the left eye has a fibrous PED with overlying subretinal fluid extending close to the parafoveal area. Peripapillary CNV can fluctuate over time but is usually self-limited without foveal involvement. Observation is recommended, along with advising the patient to monitor vision with an Amsler grid.
Age-related macular degeneration (AMD) is a progressive retinal disease characterized by drusen accumulation, pigmentary changes, and in some cases, choroidal neovascularization (CNV). Peripapillary CNV is a variant where neovascular membranes develop near the optic nerve head, often sparing the fovea and showing a chronic, fluctuating course. Optical coherence tomography (OCT) findings typically include pigment epithelial detachments (PEDs) and subretinal fluid. Careful monitoring is essential to detect any progression involving the central macula..
✔ Deliver the highest standards of care
✔ Increase patient satisfaction and retain patients
✔ Stimulate revenue
Peripapillary choroidal neovascularization in AMD tends to have a more benign course than classic CNV, with less frequent involvement of the fovea and slower progression.
Jampol LM, Sloan FA, Blodi BA, et al. Clinical features and natural history of peripapillary choroidal neovascularization. Arch Ophthalmol. 1990;108(7):945–949. doi:10.1001/archopht.1990.01070190331020